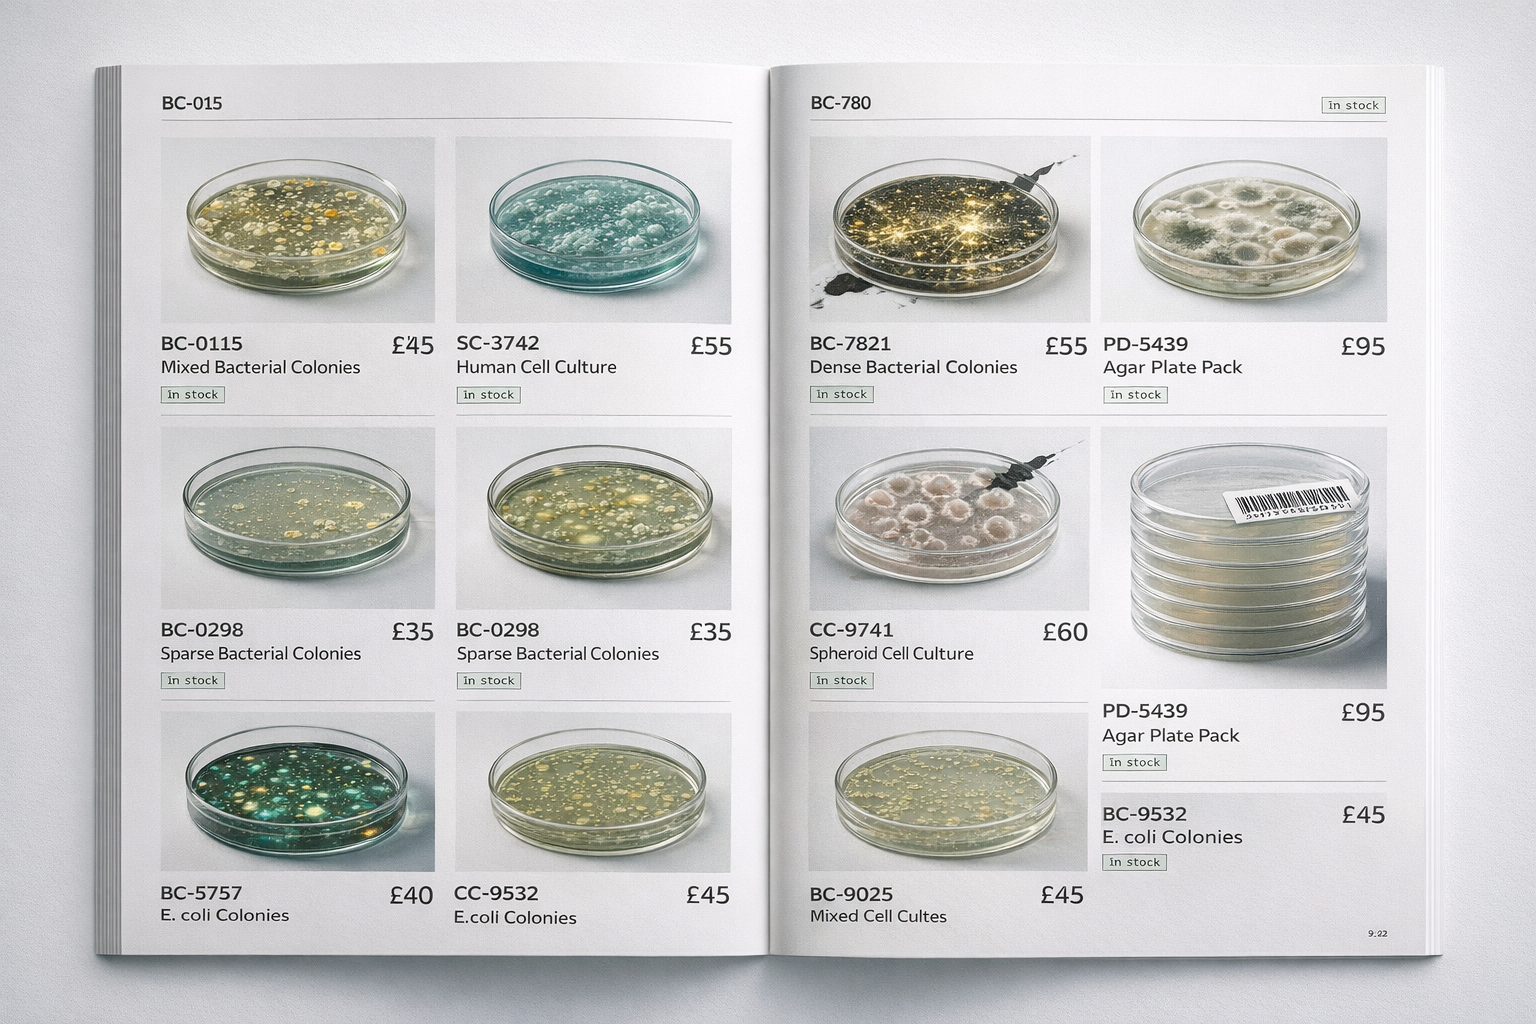
Обезьяна с автоклавом - 6

Или почему 0.01% биомассы не имеют права решать за остальные 99.99%
Сегодня утром я закончил примерно десять миллиардов жизней, а потом пошёл обедать с коллегами. Звучу как потенциально успешный политик образца 2026 года, но речь не о том. Руки пахли автоклавированным LB-бульоном, а на столе стояли шесть чашек Петри с E. coli DH5α, которые я залил лизирующим буфером, потому что мне нужна была плазмидная ДНК. Кишечные палочки не вопили от боли, естественно не страдали от моих манипуляций, но всё же я их убил.
Этический комитет моего института об этом не знает. Не потому что я скрываю, а потому что никакого этического комитета у нас нет. Потому что ему нечего регулировать. Принцип 3R Рассела и Бёрча (1959) заканчивается ровно там, где начинаются прокариоты. Ноль документов. Ноль согласований. Ноль угрызений совести.
Нуууу, почти ноль.
Около месяца назад я написал статью, где пытался объяснить одну неудобную вещь. Наука работает с моделями, а не с реальностью. Наши кварки, наши поля, наша стандартная модель. Всё это работает (и работает блестяще), но это не «как устроен мир». Это золотые гвозди, вбитые в хрустальную сферу. Предсказания сходятся, спутники летают, а мы по-прежнему смотрим через щель в заборе и описываем слона по хвосту.
Тогда я не договорил, остановился на эпистемологии. Мы знаем меньше, чем думаем, наши сенсоры ограничены, модели хрупки. Конечно-конечно, всё так. Но из этого следует кое-что практическое, о чём я промолчал, неумышленно, лишь потому что не мог сформулировать, не выглядя при этом как городской сумасшедший.
Теперь могу (и всё равно буду выглядеть именно так, или как бородатая Грета Тунберг 29 лет).
Так вот, друзья мои хабровцы: если мы работаем с моделями, а не с реальностью; если наши сенсоры ловят щёлочку спектра; если мы понимаем, по самым щедрым оценкам, процентов пять того, что происходит вокруг. Тогда на каком основании мы решаем, что ценно, а что нет?
Один дофига самоуверенный пиксель
Представьте фотографию в десять мегапикселей. Один из этих пикселей вдруг обретает сознание. Оглядывается. Видит ближайших соседей, парочку красных, одного зелёного, синий через два ряда. Строит модель картины. Объявляет себя главным. И начинает удалять всё, что не вписывается в его представление о гармонии.
Мы и есть этот пиксель.
По данным Bar-On, Phillips и Milo (PNAS, 2018), общая биомасса Земли составляет примерно 550 гигатонн углерода. Растения составляют 450 Гт (82%). Бактерии 70 Гт (13%). А Homo sapiens? 0.06 Гт. Ноль целых ноль одна сотая процента. Это буквально один пиксель из десяти тысяч.
У этого пикселя есть автоклав.

Птолемей с этической комиссией
Логика простая, я разложу по шагам.
Ранее мы вынесли, что оперируем моделями, не реальностью. Каждая модель вырезает кусок из чего-то большего и называет этот кусок «миром». Работает? Ну так. ЛАДНО, работает. Полноценно? Нет.
Дальше, у человека просто нереальные сенсорные ограничения. Человеческое восприятие покрывает ничтожную долю того, что вообще можно воспринимать. Мы не видим ультрафиолет, не слышим инфразвук, не чувствуем магнитные поля. А бактерии, к слову, чувствуют. Магнитотактические бактерии ориентируются по геомагнитным линиям.
Из этого следует, что мы не знаем достаточно, чтобы определить, что ценно, а что нет.
И вот ради чего я всё это затеял. Ставить себя в центр этической вселенной — не вывод из знания. Это заполнение пустоты собой. Геоцентрическая система в этике. Птолемей с эпициклами, только вместо планетных орбит моральные категории, а вместо «Земля в центре» стоит «человек решает, кому жить а кому – страдать».
В XV веке нужна была смелость Коперника (у меня такой нет), чтобы сдвинуть Землю из центра космоса. Может, пора сделать что-то подобное с этикой. Или хотя бы задуматься.
Термодинамика против пафоса
В 1944 году Шрёдингер написал «What is Life?» и ввёл понятие негэнтропии. Организм, говорит он, питается отрицательной энтропией. Вытягивает порядок из окружающей среды и отдаёт обратно хаос (тепло, углекислоту, мочевину, если повезёт). Красивая идея, туманненькая, притягательная. Семьдесят лет её цитировали на банкетах, не очень понимая, что с ней делать.
А в 2013-м Джереми Ингланд из MIT взял и посчитал. Его теория диссипативной адаптации сводится к следующему. Есть система, получающая энергию извне (солнце, гидротермальный источник, разлом в океанском дне). Эта система будет самоорганизовываться. Не «может», не «иногда». Будет. Потому что структуры, которые лучше рассеивают энергию, термодинамически выгоднее. Жизнь, по Ингланду, не чудо и не случайность. Жизнь — то, что делает материя, когда через неё проходит достаточно энергии.
Так, стоп. Я сейчас звучу как евангелист популяризатор. Переключусь на конкретику.
В 2016 году группа Вентера (да, того самого, который секвенировал геном человека наперегонки с государством) создала JCVI-syn3.0, синтетическую клетку с минимальным геномом. 473 гена. Абсолютный минимум, при котором штука ещё жива, ещё делится, ещё остаётся клеткой. Из этих 473 генов 149 имеют неизвестную функцию. Тридцать один с половиной процент.
Стоит вчитаться. Мы убрали из клетки всё лишнее. Оставили только необходимое. И треть необходимого мы не понимаем.
Мы не понимаем КАК МИНИМУМ трети сложности того, что по-приколу уничтожаем. Под приколом я разумеется подразумеваю улучшение уровня жизни человека, и это совершенно точно абсолютно зловредная тенденция, но об этом как-нибудь потом.
Когда я утром заливаю культуру лизирующим буфером, я разрушаю машину, которую не смог бы собрать заново. Да, мне нужна плазмида. Да, я получу её и поставлю эксперимент, и напишу статью, получу премию в 4823 рубля до вычета налогов, себе возьму пивко, детям мороженое. Но между строчками протокола где-то теряется тот факт, что десять миллиардов раз была разрушена система, чью инструкцию мы прочитали на две трети.
Так себе инженерный подход, если честно.

Масштаб того, что мы делаем
Цифры, которые я сейчас приведу, не новые. Но сложенные вместе, они производят странный эффект. Как мозаика из деталей, каждая из которых по отдельности «ну окей», а вместе дают эффект «wait what?».
Дикие млекопитающие составляют 4% от биомассы всех млекопитающих (Greenspoon et al., PNAS, 2023). Четыре процента. Скот 60%, люди 36%. Дикие наземные млекопитающие в сумме весят примерно 20 миллионов тонн. Это по три килограмма на каждого из нас.
Семьдесят процентов всех птиц на планете, конкретно прямо сейчас, это домашние куры. Не «домашняя птица вообще». Куры, курочки. Gallus gallus domesticus.
83 миллиарда наземных животных убиваются ежегодно (FAO, 2022). Сто с лишним миллионов лабораторных. Скорость вымирания видов в 100-1000 раз выше фоновой (Ceballos et al., Science Advances, 2015). Фоновая скорость — то, с какой виды вымирали миллионы лет до нас. Мы ускорили процесс в три порядка.
А теперь про бактерий.
Sender et al. (PLoS Biology, 2016) пересчитали знаменитое соотношение «в теле человека бактерий в 10 раз больше, чем собственных клеток». Оказалось, враньё. Соотношение примерно 1.3:1. Но даже 1.3:1 означает, что в вашем теле прямо сейчас больше бактериальных клеток, чем ваших собственных. Вы, строго говоря, немного бактерия (а один мой коллега даже не немного).
Лабораторные штаммы E. coli, Lactococcus, Saccharomyces прошли тот же путь, что крупный рогатый скот. Одомашнивание. Геномная редукция, потеря генов, ненужных в комфортных условиях. Зависимость от человека. Утрата «дикого» фенотипа. Лабораторная кишечная палочка не выживет в кишечнике. Она слишком привыкла к LB-среде и 37 градусам в термостате.
Мы одомашнили бактерий, как коров. С той разницей, что коровам полагается ветеринар, а E. coli DH5α полагается бодрящий, стоградусный автоклав (Вспомните своего деда и его “Еле теплую русскую баньку”, от которой золотые зубы плавятся и капают на коленки).
Тест, от которого дёргается глаз
Вот мысленный эксперимент, который я ставил себе в три часа ночи (не повторяйте дома, чревато бессонницей).
E. coli не умна. У неё нет нервной системы, нет ничего даже отдалённо похожего на субъективный опыт. Но она жива. Она метаболизирует, делится, реагирует на среду, мутирует, эволюционирует. Четыре миллиарда лет непрерывной линии. От LUCA до той конкретной колонии, которую я утром смыл в раковину.
ChatGPT (или любая другая LLM) не жива. Нет метаболизма, нет клеточной мембраны, нет эволюционной истории. Но по любому стандартному тесту на «интеллект» она разносит бактерию в пух и прах. Пишет сонеты, решает дифуры, поддерживает беседу о Канте. Ещё и не устаёт.
Теперь вопрос. Если моральный статус определяется интеллектом, то ChatGPT важнее кишечной палочки. И важнее большинства животных. И, будем честны, важнее некоторых людей по понедельникам до кофе.
Если моральный статус определяется жизнью (той самой, с метаболизмом и негэнтропией), тогда у E. coli он есть, а у GPT нет. И у червя есть. И у автоклавированного миллиарда маленьких дружелюбных бактерёх («Вот у ней глаз, вот у ней рот), о котором никто не спрашивает.
Критерий выбирает тот, кто у власти.
Мы выбрали «сложный интеллект» не потому, что это объективно верный критерий. А потому, что по нему мы выигрываем. Удобно. Как выбирать правила игры после того, как посмотрел карты.
Аристотель ставил рабов ниже свободных греков (другая природа, логично же). Декарт объявил животных автоматами (кричат, но не страдают, просто механика). Бентам в 1789-м впервые спросил: «Вопрос не в том, могут ли они мыслить, а в том, могут ли они страдать». Сингер в 1975-м назвал всё это спесиецизмом (speciesism). Тейлор в 1986-м дошёл до биоцентризма.
А вот бактериями академическая этика заинтересовалась только в 2020-х. Через тридцать пять лет после Тейлора. Двести тридцать после Бентама. Два с половиной тысячелетия после Аристотеля.
Мы очень медленно расширяем круг.
Когда оппонент прав (к моему дичайшему неудовольствию)
Я слышу возражение. Оно очевидное, и оно сильное, и я не собираюсь делать из него соломенное чучело.
«Биоцентризм абсурден в своём логическом пределе. Если у каждой бактерии есть моральный статус, то помыть руки с мылом значит совершить геноцид. Принять антибиотик, выписанный врачом, значит стать серийным убийцей. Иммунная система ежедневно уничтожает миллиарды клеток (костный мозг производит свыше 100 миллиардов нейтрофилов в сутки, и каждый из них живёт, чтобы убить). Если это всё “этически значимо”, то этика парализует жизнь. Она становится невозможной. Буквально. Потому что жить значит убивать.»
Всё так.
Но.
Лев убивает антилопу не потому, что провёл этическую калькуляцию и решил, что его жизнь ценнее. Он убивает, потому что он лев. У него нет выбора. У иммунной системы нет выбора. У антибиотика в крови нет выбора.
У меня — есть.
Когда я утром достаю чашки Петри из инкубатора, я могу взять одну колонию вместо шести. Могу оптимизировать протокол так, чтобы тратить меньше культуры. Могу (теоретически) задуматься о том, нужен ли этот конкретный эксперимент вообще, или я гоню пилот, потому что грант горит.
И ещё одно. «Это неудобно» никогда не было аргументом против истинности. Гелиоцентризм был чудовищно неудобен. Он означал, что Земля не центр мироздания, что Библию нельзя читать буквально, что весь космологический порядок средневековья летит к чертям. Инквизиция сожгла Бруно и заставила Галилея отречься не потому, что они опровергли гелиоцентризм. А потому, что он был неудобен.
Неудобство принадлежит тому, кто применяет, а не тому, что применяется.
Если расширение этического круга на всю жизнь кажется абсурдным и парализующим, это проблема нашей этической архитектуры. Не проблема жизни.
Вопрос собственности
В 1980 году Верховный суд США вынес решение по делу Diamond v. Chakrabarty. Ananda Mohan Chakrabarty, генетический инженер из General Electric, создал штамм Pseudomonas, способный разлагать нефть. Подал патентную заявку. Патентное ведомство отказало, мол, нельзя патентовать живое. Верховный суд решил иначе. Пять к четырём.
Впервые в истории живой организм стал чьей-то интеллектуальной собственностью.
Решение писал председатель Бёргер. Ключевая фраза: «патентоспособно всё под солнцем, созданное человеком» (anything under the sun that is made by man). Четверо несогласных написали: «Конгресс при принятии патентного закона не имел в виду живые организмы». На что большинство, по сути, ответило. Ну, теперь имеет.
С тех пор мы патентуем бактерий, дрожжей, клеточные линии. Лабораторные штаммы E. coli принадлежат конкретным компаниям. У ATCC (American Type Culture Collection) есть каталог живых организмов, которые вы можете купить. С ценой, номером заказа и условиями доставки.
Я не знаю, как к этому относиться. Честно. Мне не нравится пафос «жизнь нельзя продавать», потому что мы продаём коров и свиней, и никто не хватается за сердце. Но есть что-то скрипучее в самой идее, что систему, которую мы понимаем на две трети и не можем создать с нуля, можно положить в каталог между пипетками и наконечниками.
Молекулы жизни обычны. Жизнь нет
В сентябре 2023-го NASA опубликовала результаты анализа грунта, доставленного миссией OSIRIS-REx с астероида Бенну. Рибоза. Аминокислоты. Нуклеотидные основания. Строительные блоки жизни. На камне, летающем в вакууме между Марсом и Юпитером, при температурах, при которых мой LB-бульон стал бы стеклом.
Молекулы жизни обычны. Они возникают спонтанно, потому что химия так работает. Ингланд был прав. При наличии энергии и нужных элементов самоорганизация неизбежна.
Но сама жизнь. Живая клетка, с мембраной, с метаболизмом, с генетическим кодом, с четырьмя миллиардами лет эволюционной истории. Мы пока знаем ровно одну планету, где это случилось. Одну.
Как река. Волна в океане тоже неизбежна. Ветер дует, вода колеблется, волна появится. Но конкретная река, с её руслом, с её поворотами, с тем кустом на левом берегу и той форелью на перекате, конкретная река уникальна. Её нельзя «переделать». Можно запрудить и получить что-то другое.
Мы каждый день запруживаем реки, которых не видим.
Пиксель, который увидел краешек
Я знаю, о чём вы думаете. «Ну и что теперь? Закрыть лаборатории? Запретить антибиотики? Умереть от сепсиса ради моральной чистоты?»
Нет.
Я не проповедую биоцентризм как практическую программу. Кто я такой. Молекулярный биолог из Новосибирска, который утром убил десять миллиардов бактерий и пишет об этом статью на Хабр. Какой из меня этический авторитет.
Я вот к чему. Ощущение дискомфорта, которое возникает при мысли о масштабе того, что мы делаем с биосферой. Оно ценно само по себе. Его не нужно «решать». Его нужно не заглушать.
Мы, 0.01% биомассы, перекроили планету. Шестьдесят процентов млекопитающих на Земле существуют, потому что мы их едим. Семьдесят процентов птиц существуют, потому что мы их едим. Четыре процента диких млекопитающих. Четыре. Вымирание идёт в сто-тысячу раз быстрее фонового. Мы одомашнили бактерий и даже не заметили.
И всё это один пиксель. Один, из десяти тысяч, с точки зрения биомассы. Решающий за всю картину.
Шрёдингер. Жизнь питается негэнтропией. Строит порядок из хаоса. Это единственный известный нам процесс во Вселенной, который систематически увеличивает сложность. Звёзды синтезируют тяжёлые элементы, да. Но жизнь берёт эти элементы и строит из них нечто, чего физика «сама» не строит. Мембрану. Рибосому. Глаз. Мозг. Статью на Хабре о том, что жизнь строит сложность.
Уничтожать эту сложность, не понимая трети её минимальной единицы (помните 149 генов из 473 у JCVI-syn3.0?), и при этом быть уверенным, что «ничего страшного, они же не чувствуют». Это не наука. Это антоним науки. Наука начинается с «я не знаю» и ведёт себя соответственно.
«Они же не чувствуют»
Самый популярный аргумент. Я слышу его от коллег по три раза в неделю. Бактерии не чувствуют боли. У них нет нервной системы. Нет ноцицепторов. Нет субъективного опыта. Значит, нет морального статуса.
Ладно.
До 1980-х годов считалось, что новорождённые дети не чувствуют боли. Их оперировали без анестезии. Серьёзно. Jill R. Lawson в 1986 году опубликовала в журнале Pain статью, где описала, что младенцам проводили операции на открытом сердце с мышечными релаксантами (чтобы не дёргались), но без обезболивания. Потому что «нервная система незрелая» и «они не помнят».
Нервная система была незрелая. Они не помнили. Но они чувствовали.
Вопрос «чувствуют ли бактерии» предполагает, что мы знаем, что такое «чувствовать». Мы не знаем. У нас нет теории сознания. Есть набор гипотез (IIT, Global Workspace, Higher-Order Theories), ни одна из которых не стала общепринятой, и ни одна не может строго ответить на вопрос, где именно проходит граница субъективного опыта.
Мы проводим эту границу там, где удобно. И двигаем, когда становится неудобно.
Утро, продолжение
Завтра в восемь тридцать я зайду в лабораторию, надену перчатки, достану из холодильника компетентные клетки DH5α и начну трансформацию. Прогрею на 42 градусах (тепловой шок, 45 секунд, ни секундой больше). Высею на селективную среду с ампициллином. Те, кто не взял плазмиду, умрут. Те, кто взял, дадут колонии к утру послезавтра. Я отберу одну, проверю инсерт секвенированием. Если повезёт, наращу культуру и выделю белок.
Я буду это делать. Не потому что не понимаю. Потому что понимаю. И всё равно делаю.
Это не лицемерие. Или, может, лицемерие, но единственное честное лицемерие, которое мне доступно. Мы живём внутри противоречия, у которого нет решения на нашем уровне знания. Жизнь на этой планете устроена так, что жизнь поддерживает себя через поедание жизни. Клетка лизирует клетку. Нейтрофил пожирает бактерию. Бактерия разлагает нейтрофил. Человек автоклавирует бактерию. Круг.
Этика жизни на такой планете не может быть сводом правил. Она может быть только открытой раной. И зашить эту рану притворством «они ничего не чувствуют» или «они не считаются» хуже, чем оставить открытой. Потому что зашитая рана гноится, а открытая, по крайней мере, честна.
Швейцер назвал это «благоговением перед жизнью» ещё в 1923 году. Звучит пафосно, я знаю. Звучит как название подкаста для мамочек. Но Швейцер при этом был врачом в Ламбарене и каждый день принимал решения, кто получит лекарство, а кто нет. Он не витал в облаках. Он резал и зашивал и знал, что благоговение перед жизнью не освобождает от необходимости убивать. Оно освобождает от иллюзии, что убивать нормально.
Краешек картины
Помните пиксель? Один из десяти миллионов, который вдруг обрёл сознание и начал удалять соседей?
Вот чем наш пиксель отличается от остальных. Он впервые посмотрел дальше ближайших соседей. OSIRIS-REx принёс нам молекулы с астероида. Телескоп Джеймса Уэбба показал атмосферы экзопланет. Секвенаторы читают геномы организмов, которых мы ещё не видели в микроскоп. Мы, один пиксель, впервые увидели краешек картины.
И картина оказалась сложнее, чем мы думали. Намного. На 31.5% минимального генома «мы понятия не имеем, что это делает» сложнее. На «четыре миллиарда лет непрерывной цепочки, которую нельзя перезапустить» сложнее.
Вот что забавно. Мы можем посадить зонд на астероид, собрать грунт и доставить его на Землю. Можем отредактировать геном эмбриона (привет, He Jiankui, как тюрьма?). Можем синтезировать клетку с минимальным геномом и не понять треть того, что синтезировали.
Но мы не можем решить простой вопрос. Имеет ли значение то, что я убиваю каждое утро?
Может, и нет. Может, бактерии, это просто химия. Молекулярные автоматы. Декарт был прав, просто недостаточно радикален. Может, и мы автоматы, просто посложнее, и весь этот текст — автомат, обманывающий себя, что ему не всё равно.
А может, жизнь, любая жизнь, это что-то такое, что заслуживает хотя бы паузы перед нажатием кнопки автоклава. Не запрета. Паузы.
Я не знаю.
Но я больше не могу не знать и не думать об этом.
Мы один пиксель. Пиксель, который впервые увидел краешек картины. И теперь не может развидеть.
Автор: DeMoivre


